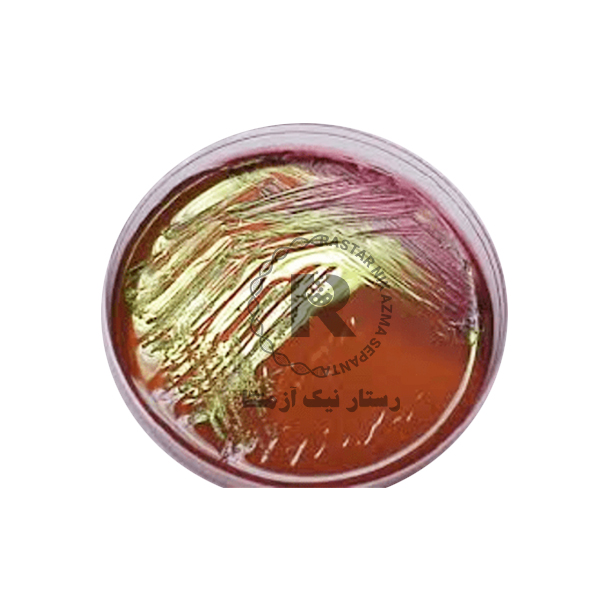
محیط کشت ائوزین متیلن بلو(EMB) کیولب

مشخصات محصول:
محیط کشت ائوزین متیلن بلو (EMB) یک محیط کشت افتراقی-انتخابی مفید برای جداسازی باکتری های روده ای گرم منفی روده ای است. رنگ های ائوزین و متیلن موجود در محیط اجازه رشد باکتری های گرم مثبت را نمی دهند.
ویژگی محیط کشت ائوزین متیلن بلو(EMB) کیولب
- تفکیک بر اساس تخمیر لاکتوز
- محیطPHتغییر رنگ محیط براساس تغییر
کاربرد محیط کشت ائوزین متیلن بلو(EMB) کیولب
- از طریق کلنی های آبی-سیاه با درخشندگی بالا در محیط جهت تشخیص باکتریE.coli
- تشخیص انتروباکتر از طریق تشکیل کلنی های صورتی
نظرات دوستان